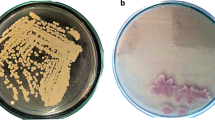

Abstract
Laccases produced by Leucoagaricus gongylophorus act in lignocellulose degradation and detoxification processes. Therefore, the use of L. gongylophorus laccase (Lac1Lg) was proposed in this work for degradation of anthracene and others polycyclic aromatic hydrocarbons without the use of mediators. Degradation reactions were performed in buffer aqueous solution with 10 ppm of anthracene and other PAHs, Tween-20 in 0.25% v/v and a laccase preparation of 50 U. The optimum condition (pH 6.0 and 30 °C) was determined by response surface methodology with an excellent coefficient of determination (R2) of 0.97 and an adjusted coefficient of determination (R2adj) of 0.93. In addition, the employment of the mediator ABTS decreased the anthracene biodegradation from 44 ± 1% to 30 ± 1%. This optimum pH of 6.0 suggests that the reaction occurs by a hydrogen atom transfer mechanism. Additionally, in 24 h Lac1Lg biodegraded 72 ± 1% anthracene, 40 ± 3% fluorene and 25 ± 3% phenanthrene. The yellow laccase from L. gongylophorus biodegraded anthracene and produced anthrone and anthraquinone, which are interesting compounds for industrial applications. Moreover, this enzyme also biodegraded the PAHs phenanthrene and fluorene justifying the study of Lac1Lg for bioremediation of these compounds in the environment.
Similar content being viewed by others
Explore related subjects
Discover the latest articles, news and stories from top researchers in related subjects.Avoid common mistakes on your manuscript.
Introduction
The fungus Leucoagaricus gongylophorus lives in a mutualistic relationship with cutting ants of the Atta and Acromyrmex genera. Several studies involving this microorganism have been conducted to understand its role and the importance of its enzymes to ants (Aylward et al. 2015). Some of these studies suggest that the produced enzymes, including laccases, act in the lignocellulose degradation and in detoxification processes, oxidizing compounds originated from the metabolism of plants (Aylward et al. 2013; Licht et al. 2014).
Laccases (1.10.3.2 ECF, p-diphenol: oxygen oxidoreductase) are a class of enzymes that oxidizes aromatic and non-aromatic compounds (Filazzola et al. 1999). Unlike other ligninolytic enzymes such as manganese peroxidase (MnP) and lignin peroxidase (LiP), which require hydrogen peroxide to exert their activity, laccases catalyze the substrates oxidation with oxygen as electron acceptor (de la Rubia et al. 2002). Because of this property, laccases are enzymes with high potential for biotechnological applications, in which they can be employed as biocatalysts in organic synthesis and in biodegradation processes (Kudanga et al. 2017; Riva 2006).
Laccases contain four copper atoms and a maximum absorption at 600 nm responsible for the intense blue color of these enzymes (Madhavi and Lele 2009). Blue laccases from different microorganisms have been employed for biodegradation of polycyclic aromatic hydrocarbons (PAHs), such as CotA from Bacillus subtilis, CueO from Escherichia coli (Zeng et al. 2016), and laccase from Trametes villosa (Prasetyo et al. 2016).
However, there are laccases that do not absolve at 600 nm and are called yellow or yellow/white laccases (Leontievsky et al. 1997). Blue laccases usually require the use of chemical mediators to catalyze reactions in non-phenolic compounds, differently from yellow laccases that shows modifications in the type 1 copper and perform reactions directly in this type of substrates (Bourbonnais and Paice 1992; Huang et al. 2011).
Yellow laccases have been studied without mediators for different applications, including the decolorization of the dyes Reactive Black 5, Remazol Brilliant Blue R, Reactive Red 195, Reactive Yellow 145 (Marim et al. 2016), the transformation of toluene and substituted derivatives to the corresponding benzaldehydes (Sharma et al. 2016) and the oxidation of ethyl ferulate and ferulic acid (Aljawish et al. 2014).
PAHs are a class of organic compounds composed by two or more fused aromatic rings, which can be formed during the thermal decomposition of organic molecules and their subsequent recombination (Bamforth and Singleton 2005). The burn of fossil fuels like coal and oil, and volcanic eruptions are examples of natural sources of PAHs. However, most of these compounds are produced by human activity, as the burning of diesel, wood, plastic, plant material, trash, and lubricating oil (Haritash and Kaushik 2009). Given the highly recalcitrant and toxic nature of these substances, PAHs are considered worrying and widespread pollutants (Ghosal et al. 2016; Brewster et al. 2018).
The activity of a laccase is intrinsically related to the pH and temperature of the reaction medium (Xu 1997). Response surface methodology (RSM) is an effective set of statistical and mathematical tools for optimizing processes in a faster and more economical approach when compared to the classical one-variable-at-a-time method (Myers et al. 2009). In this context, RSM is a useful method to evaluate how the variables pH and temperature affect the efficiency of the laccase from L. gongylophorus on PAHs biodegradation and to determine how the combination of these variables allow the highest degradation result.
The use of isolated laccases and microorganisms for PAHs degradation has been reported in several studies. However, the degradation depended on mediator molecules like 2,2′-azino-bis(3-ethylbenzothiazoline-6-sulfonic acid) (ABTS) or 1-hydroxybenzotriazole (HBT) in most of the literature, reducing the reaction efficiency and increasing the process cost (Chang et al. 2016).
A monomeric yellow laccase from the fungus L. gongylophorus (Lac1Lg) was identified and characterized in a previous work and was able to oxidize wide non-phenolic substrate (anthracene) in the absence of exogenous mediators, despite having a very closed catalytic site. Therefore, showing potential for future biotechnological processes (Ike et al. 2015).
In this work, we proposed the use of Lac1Lg for anthracene biodegradation using RSM for the determination of the optimized pH and temperature of the reaction. Exploring, in addition, the biodegradation of different PAHs such as fluorene, fluoranthene, phenanthrene, and pyrene to expand the application scope of this recently discovered enzyme.
Materials and methods
Fungus culture
L. gongylophorus strain FF-2006 was isolated from a Atta sexdens rubropilosa nest and was maintained in a solid medium of 2% malt extract, 0.5% bacteriological peptone, 0.2% yeast extract and 2% agar (Bicalho 2011).
Laccase preparation
The laccase preparation was performed as carefully described by Ike et al. (2015). The mycelium was cultivated in modified Tien and Kirk medium without dimethyl succinate at 25 °C for 11 days, and then lyophilized (Tien and Kirk 1988). Subsequently, the enzymatic extract was dialyzed and applied in ionic exchange chromatography with a hydroxyapatite column (CHTTM ceramic hydroxyapatite type I, 1.5 cm × 12 cm, Bio-Rad). The elution was performed with 400 mM sodium phosphate pH 5.8 with 0.0075 mM CaCl2 (solvent B) in a linear gradient mode (0–100%B). The fractions with laccase activity were dialyzed with a 50 mM sodium phosphate solution pH 7.0 and concentrated ten times with a Amicon Ultra-15 (Millipore) ultrafiltration system.
Determination of laccase activity
The laccase activity was measured by the oxidation of syringaldazine as described by Ike et al. (2015). The assay contained 10 μL of enzymatic solution and 10 μM of syringaldazine in a total volume of 0.5 mL of 20 mM aqueous sodium acetate buffer (pH 6.0). The determination of the oxidation reaction was carried out at 525 nm with the extinction coefficient of 65,000 M−1 cm−1. One unit of laccase activity was defined as the amount of enzyme necessary to oxidize 1 μmol of substrate per minute (Jordaan 2005; Wolfenden and Willson 1982).
PAHs degradation
The degradation of PAHs by the partially purified laccase was initially evaluated using anthracene. Anthracene-stock solutions were prepared at a concentration of 1000 ppm using DMSO as solvent. Degradation reactions were performed in aqueous buffer (in the evaluated pH) containing anthracene at a final concentration of 10 ppm, laccase preparation (50 U) and 0.25% v/v of the detergent Tween-20 (Sigma). The final volume of the reactions was 5 mL. For the pHs 5 and 6, 20 mM of sodium citrate aqueous buffer solution was employed, whereas 20 mM sodium phosphate buffer was used for reactions at pH 7. The reactions were kept under controlled temperature and magnetic stirring (100 rpm). The pH and temperature of the reaction medium were defined as described in the Experimental Design section. After 24 h, the residual PAH was recovered by three liquid-liquid extractions with an equal volume of ethyl acetate (5 mL). The organic phase was dried with anhydrous sodium sulfate, filtered, and then evaporated under reduced pressure at 30 °C. The product was then dissolved in 1 mL of acetonitrile. The temperature and pH that allowed the highest anthracene degradation was also applied to evaluate the degradation of fluorene, fluoranthene, phenanthrene and pyrene in the same reactional conditions.
Experimental design
A 22 central composite rotatable design was used to analyze the main effects and interactions of the variables pH and temperature on the residual concentration of anthracene. Based on preliminary experiments, the independent variables and their levels were selected as shown in Table 1. A total of 11 experiments were carried out, consisting of 4 factorial experiments, 4 axial experiments, and 3 replicates of the center point. All the experiments were carried out at random to minimize systematic errors.
Quantification of PAHs biodegradation
PAHs were quantitatively analyzed by a validated method employing a Shimadzu high pressure liquid chromatographic system composed of an LC-20AT pump, a DGU-20A5 degasser, a SIL-20AHT sampler, a SPD-M20A UV-VIS detector, a CTO-20A column oven, and a CBM-20A controller. The separation was performed using a reverse phase C18 column (Shim-pack CLC-ODS column, 25 cm × 4.6 mm × 5 µm). For elution, it was employed a linear concentration gradient of 40–95% water/acetonitrile from 0 to 30 min using a flow rate of 1.0 mL min−1. Standard curves were produced with standard solutions of 10, 20, 30, 40, 50, and 60 mg L−1 for each analyte, i.e., anthracene (357 nm), fluorene (299 nm), fluoranthene (286 nm), phenanthrene (250 nm) and pyrene (334 nm). Chromatograms and analytical curves are presented in Electronic Supplementary Material-1, Fig. S1–10.
Method recovery
Experiments for determination of the method recovery were performed in the same biodegradation reactional conditions (pH 6.0, 30 °C) without the enzyme. Therefore, a method recovery was estimated for anthracene, phenanthrene, fluoranthene, fluorene and pyrene.
Metabolite identification
The metabolites were analyzed by gas chromatography coupled with mass spectrometry (GC-MS) in a Shimadzu GC2010 plus with a mass selective detector (Shimadzu MS2010 plus) in electron ionization mode (EI, 70 eV). The GC-MS (equipped with a 30 m × 0.25 mm × 0.25 μm J&W Scientific DB5 column) conditions were oven temperature starting at 90 °C for 4 min, increased to 280 °C at 6 °C min−1, and held for 6 min; injector and interface temperature was maintained at 250 °C; splitless 1 μL injection; helium as carrier gas at a constant flow of 0.75 mL min−1; and 40 min of analysis time. The employed scan mode was 40–500 m/z.
Statistical analysis
Multiple regression analysis was used to fit a second-order polynomial equation (Eq.1) to the experimental data collected from the 22 central composite rotatable design by the least-squares method (Calado and Montgomery 2003).
where Y represents the predicted response, β0 is the model intercept, β1 and β2 are the linear coefficients, β1β2 are the interaction coefficient, β11 and β22 are the quadratic cofficients, and ε corresponds to the model residue (Calado and Montgomery 2003).
The statistical significance of the independent variables on the response was determined by the evaluation of the p value and Fisher’s test with 95% significance level obtained from the analysis of variance (ANOVA). The fit of the model was expressed by the coefficient of determination (R2) and the adjusted coefficient of determination (R2adj). The three-dimensional surface plot was produced using the fitted model to illustrate the relationship between the independent variables and the response, aiming the determination of the optimal conditions of pH and temperature which result in the highest anthracene degradation. All calculations and graphics were obtained by the Statistica software (Statsoft version 7.0, USA) (Calado and Montgomery 2003; Montgomery 1991).
Results
Method recovery
A method validation was carried out without enzyme and a residual anthracene of 50.1 ± 1.5 mg L−1 was determined, showing that the employed methodology presented a method recovery of 100.2% with a standard deviation of 3% for anthracene.
Validation experiments were also performed for the others PAHs, including phenanthrene (47.4 ± 1.0 mg L−1, 94.8% recovery and 2.0% precision); fluorene (42.2 ± 1.4 mg L−1, 84.4% recovery and 2.8% precision); fluoranthene (40.1 ± 1.2 mg L−1, 80.2% recovery and 2.4% precision); and pyrene (40.3 ± 1.5 mg L−1, 80.6% recovery and 3.0% precision). Therefore, the determination method employed in this study was adequate.
Optimum pH and temperature
A factorial design was employed to determine the best conditions of pH and temperature for carrying out the anthracene degradation experiments. Table 2 shows the coded (in parenthesis), the uncoded independent variables (pH and temperature) and the experimental values of the response variable, residual anthracene concentration. Multiple regression analysis was used to fit Eq. 1 to the experimental data aiming to describe the relation between the dependent variables and the independent variables. The statistical significance of the model fit was determined by analysis of variance (ANOVA) at a confidence level of 95% (p value < 0.05), and the results were presented in Table 3. The significance of each term was evaluated by the F-test and p value, in which the corresponding terms are more significant if the absolute F value becomes bigger and the p value becomes smaller.
The quadratic term of temperature (X22) had the greatest influence on anthracene degradation, and the quadratic term of pH (X12) was the second most important factor, as observed in Table 3. In addition, the linear term temperature (X2) and the interaction between pH and temperature (X1.X2) were also significant (p value < 0.05). The regression equation obtained for the residual anthracene concentration without non-significants terms was given in Eq. 2:
The model adequacy was evaluated by the coefficient of determination (R2) and the adjusted coefficient of determination (R2adj) whose values were 0.9672 and 0.9344, respectively. Showing that the fitted model could explain above 93% of the total variability within the range of this study and that the experimental values could be significantly predicted by the model. A three-dimensional surface was generated based on Eq. 2 and was shown in Fig. 1. The response surface plot shows that the lowest residual concentration of anthracene was observed at pH 6 and 30 °C of temperature.
It is important to note that a method validation was carried out and a residual anthracene of 50.1 ± 1.5 mg was determined, showing that the employed methodology presented a method recovery of 100.2% with a standard deviation of 3.0%. Therefore, the used method for anthracene determination in this study was adequate.
An additional experiment with the addition of the mediator ABTS (1.0 mM) was carried out at 30 °C and pH 6.0, in which a residual anthracene of 35.1 ± 0.5 mg mL−1 (29.8 ± 1.0% biodegradation) was determined. Showing that the process efficiency is reduced by the addition of this mediator, since a residual anthracene of 28.2 ± 0.4 mg mL−1 (43.6 ± 0.8% biodegradation) was obtained without ABTS in the same reactional conditions.
The biodegradation of anthracene resulted in the formation of anthrone and mainly anthraquinone (Fig. 2). Chromatograms and spectra are available in Electronic Supplementary Material 2 and 3, Fig. S11–15. Showing that the laccase from L. gongylophorus was able to oxidize anthracene and produce valuable products for future applications.
Biodegradation of others PAHs
Biodegradation reactions with fluorene, phenanthrene, fluoranthene, and pyrene were performed in the optimized conditions of anthracene biodegradation, pH 6.0 and 30 °C. It is important to emphasize that these conditions not necessarily correspond to the optimal conditions for degradation of others PAHs.
After 24 h of reaction, anthracene and fluorene were the compounds more susceptible to oxidation by this laccase, showing 71.8 ± 0.6% and 41.7 ± 2.6% of degradation, respectively. Moreover, phenanthrene was also degraded (25.3 ± 2.6%). Unfortunately, metabolites were not observed probably because of their aqueous solubility and low concentration. Pyrene and fluoranthene biodegradation was not significant, since the residual concentrations of theses PAHs in the biodegradation experiments were similar to those determined for the method recovery (Table 4, Fig. 3).
Discussion
The major product formed by the oxidation of anthracene was anthraquinone in a reaction whose mechanism is not fully known (Ike et al. 2015). However, the oxidation of PAHs by laccases may occur by the removal of an electron from the substrate, generating a highly reactive free radical (Jeon et al. 2012).
Two mechanisms have been suggested for the electron withdraw of the reaction. In the electron transfer mechanism, the electron is withdraw from a π bond, whereas in the hydrogen atom transfer (HAT), the electron withdraw would occur by the elimination of a hydrogen atom (Canas and Camarero 2010).
The optimum pH for laccases reported in the literature is pH 4.0, for nonphenolic substrates like ABTS and, pH 6.0 for phenolic substrates such as syringaldazine. Lac1Lg presented in a previous study an optimum pH of 6.0 and 3.0 for syringaldazine and ABTS, respectively (Ike et al. 2015).
The increased efficiency in pH 6.0 determined in our study for anthracene was the same determined for syringaldazine and can be explained by a HAT mechanism, since an alkaline reaction medium would promote the proton abstraction (Canas and Camarero 2010; Farnet et al. 2009; Han et al. 2004; Munusamy et al. 2008).
The optimum temperature for anthracene biodegradation was 30 °C, which was the same determined for syringaldazine consumption, whereas the optimized temperature for ABTS was 50 °C (Ike et al. 2015), showing that Lac1Lg can catalyze PAHs reaction in mild temperature, property that can be important in future applications.
The addition of the mediator ABTS in the reaction decreased the anthracene biodegradation (29.8 ± 1.0% biodegradation and 43.6 ± 0.8% biodegradation with and without mediator, respectively), probably because the use of this compound enabled secondary reactions which reduced the process efficiency.
The biotransformation of anthracene to anthraquinone was reported in the literature by different laccase-producer fungi, such as Pycnoporus sanguineus H1 (Li et al. 2014b), Armillaria sp. F022 (Hadibarata et al. 2013) and Polyporus sp. S133 (Hadibarata et al. 2012), showing that this laccase-catalyzed reaction is important in PAHs biodegradation.
The biotransformation of anthracene by laccases can be an important approach to produce anthraquinone. Therefore, studies were described with mediators, i.e., by laccase from Trametes versicolor (Li et al. 2014a) or without mediators such as by the yellow laccase from Pleurotus ostreatus D1 (Pozdnyakova et al. 2006) and from L. gongylophorus, as reported in our study, aiming an efficient anthracene biotransformation.
Some studies relate the oxidation capacity of enzymes to the ionization potential (IP) of the approached PAH. In one of them, a lignin peroxidase of the fungus Phanaerochaete crysosporium was capable of oxidizing benzo[a]anthracene, pyrene, anthracene, benzo [a] pyrene, and perylene, whose IP values are 7.54, 7.50, 7.43, 7.06, and 7.23 eV. Whereas phenanthrene, benzo[c]phenanthrene, chrysene, and benzo[e]anthracene, whose PI values are 8.19, 7.93, 7.8, 7.62 eV were not oxidized (Hammel et al. 1986).
Similarly, the laccase-producer fungus Marasmius quercophilus was able to oxidize anthracene and benzo[a]pyrene, which PIs are smaller than 7.5, and was not able to oxidize naphthalene (IP = 8.10 eV) and phenanthrene (IP = 8.19 eV) (Farnet et al. 2009).
Based on these studies, it would be expected that the degradation of PAHs depended on their IP, so that the employed enzyme could oxidize compounds up to a certain IP maximum. However, this relationship was not observed for the Laccase from L. gongylophorus, which was not able to oxidize pyrene or fluoranthene that present low value of PI among the tested compounds, but oxidized phenanthrene which presents the highest value of PI. The observed behavior may be explained by a steric impediment, since pyrene and fluoranthene present a higher molecular weight than anthracene, phenanthrene and fluorene. However, further studies should be provided to justify these observations.
Anthracene, fluorene and phenanthrene are included on a list of the The National Waste Minimization Program of the U. S. Environmental Protection Agency, which focuses on reducing the production and use of 31 Priority Chemicals that are considered persistent, bioaccumulative, and toxic (EPA 2016).
Our results showed that the laccase from L. gongylophorus has potential for biocatalytic processes in organic synthesis or bioremediation, since it was able to oxidize these three compounds in mild conditions of pH and temperature, without the addition of mediators.
Conclusion
The yellow laccase from L. gongylophorus biodegraded anthracene without mediators and produced anthrone and anthraquinone, which are interesting compounds for industrial applications. The optimum conditions were pH 6.0 and 30 °C determined by the response surface method, which presented an excellent coefficient of determination (R2) of 0.97 and an adjusted coefficient of determination (R2adj) of 0.93. Moreover, the employment of the mediator ABTS decreased the process efficiency. This enzyme also biodegraded the PAHs phenanthrene and fluorene justifying the study of this laccase from L. gongylophorus for future bioremediation of these compounds, since they are listed as priority pollutants.
References
Aljawish A, Chevalot I, Jasniewski J, Paris C, Scher J, Muniglia L (2014) Laccase-catalysed oxidation of ferulic acid and ethyl ferulate in aqueous medium: a green procedure for the synthesis of new compounds. Food Chem 145:1046–1054. https://doi.org/10.1016/j.foodchem.2013.07.119
Aylward FO, Burnum-Johnson KE, Tringe SG, Teiling C, Tremmel DM, Moeller JA, Scott JJ, Barry KW, Piehowski PD, Nicora CD, Malfatti SA, Monroe ME, Purvine SO, Goodwin LA, Smith RD, Weinstock GM, Gerardo NM, Suen G, Lipton MS, Currie CR (2013) Leucoagaricus gongylophorus produces diverse enzymes for the degradation of recalcitrant plant polymers in leaf-cutter ant fungus gardens. Appl Environ Microbiol 79:3770–3778. https://doi.org/10.1128/AEM.03833-12
Aylward FO, Khadempour L, Tremmel DM, McDonald BR, Nicora CD, Wu S, Moore RJ, Orton DJ, Monroe ME, Piehowski PD, Purvine SO, Smith RD, Lipton MS, Burnum-Johnson KE, Currie CR (2015) Enrichment and broad bepresentation of plant biomass-degrading enzymes in the specialized hyphal swellings of Leucoagaricus gongylophorus, the fungal symbiont of leaf-cutter ants. PLoS One 10:e0134752. https://doi.org/10.1371/journal.pone.0134752
Bamforth SM, Singleton I (2005) Bioremediation of polycyclic aromatic hydrocarbons: current knowledge and future directions. J Chem Technol Biotechnol 80:723–736. https://doi.org/10.1002/jctb.1276
Bicalho KU (2011) Estudo fitoquímico de Virola sebifera associado ao controle de formigas cortadeiras. Dissertation, Universidade Federal de São Carlos
Brewster CS, Sharma VK, Cizmas L, McDonald TJ (2018) Occurrence, distribution and composition of aliphatic and polycyclic aromatic hydrocarbons in sediment cores from the Lower Fox River, Wisconsin, US. Environ Sci Pollut Res 25:4974–4988. https://doi.org/10.1007/s11356-017-0819-z
Bourbonnais R, Paice MG (1992) Demethylation and delignification of kraft pulp by Tramete-versicolor in the presence of 2,2′-azinobis-(3-ethylbenzthiazoline-6-sulfonate). Appl Microbiol Biotechnol 36:823–827. https://doi.org/10.1007/bf00172202
Calado V, Montgomery D (2003) Planejamento de experimentos usando o statistica. e-papers, Rio de Janeiro
Canas AI, Camarero S (2010) Laccases and their natural mediators: biotechnological tools for sustainable eco-friendly processes. Biotechnol Adv 28:694–705. https://doi.org/10.1016/j.biotechadv.2010.05.002
de la Rubia T, Linares A, Perez J, Munoz-Dorado J, Romera J, Martinez J (2002) Characterization of manganese-dependent peroxidase isoenzymes from the ligninolytic fungus Phanerochaete flavido-alba. Res Microbiol 153:547–554. https://doi.org/10.1016/S0923-2508(02)01357-8
Chang YT, Lee JF, Liu KH, Liao YF, Yang V (2016) Immobilization of fungal laccase onto a nonionic surfactant-modified clay material: application to PAH degradation. Environ Sci Pollut Res 23:4024–4035. https://doi.org/10.1007/s11356-015-4248-6
EPA (2016) Priority chemicals. https://archive.epa.gov/epawaste/hazard/wastemin/web/html/priority.html. Accessed 10 december 2017
Farnet AM, Gil G, Ruaudel F, Chevremont AC, Ferre E (2009) Polycyclic aromatic hydrocarbon transformation with laccases of a white-rot fungus isolated from a Mediterranean schlerophyllous litter. Geoderma 149:267–271. https://doi.org/10.1016/j.geoderma.2008.12.011
Filazzola MT, Sannino F, Rao MA, Gianfreda L (1999) Effect of various pollutants and soil-like constituents on laccase from Cerrena unicolor. J Environ Qual 28:1929–1938. https://doi.org/10.2134/jeq1999.00472425002800060032x
Ghosal D, Ghosh S, Dutta TK, Ahn Y (2016) Current state of knowledge in microbial degradation of polycyclic aromatic hydrocarbons (PAHs): a review. Front Microbiol 7:1369. https://doi.org/10.3389/fmicb.2016.01369
Hadibarata T, Khudhair AB, Salim MR (2012) Breakdown products in the metabolic pathway of anthracene degradation by a ligninolytic fungus Polyporus sp. S133. Water Air Soil Pollut 223:2201–2208. https://doi.org/10.1007/s11270-011-1016-1
Hadibarata T, Zubir M, Rubiyatno CTZ, Yusoff ARM, Salim MR, Fulazzaky MA, Seng B, Nugroho AE (2013) Degradation and transformation of anthracene by white-rot fungus Armillaria sp. F022. Folia Microbiol 58:385–391. https://doi.org/10.1007/s12223-013-0221-2
Hammel KE, Kalyanaraman B, Kirk TK (1986) Oxidation of polycyclic aromatic-hydrocarbons and dibenzo p-dioxins by Phanerochete chrysosporium ligninase. J Biol Chem 261:6948–6952
Han MJ, Choi HT, Song HG (2004) Degradation of phenanthrene by Trametes versicolor and its laccase. J Microbiol 42:94–98
Haritash AK, Kaushik CP (2009) Biodegradation aspects of polycyclic aromatic hydrocarbons (PAHs): a review. J Hazard Mater 169:1–15. https://doi.org/10.1016/j.jhazmat.2009.03.137
Huang WT, Tai R, Hseu RS, Huang CT (2011) Overexpression and characterization of a thermostable, pH-stable and organic solvent-tolerant Ganoderma fornicatum laccase in Pichia pastoris. Process Biochem 46:1469–1474. https://doi.org/10.1016/j.procbio.2011.03.020
Ike PTL, Moreira AC, de Almeida FG, Ferreira D, Birolli WG, Porto ALM, Souza DHF (2015) Functional characterization of a yellow laccase from Leucoagaricus gongylophorus. Springerplus 4(654):654. https://doi.org/10.1186/s40064-015-1464-y
Jeon JR, Baldrian P, Murugesan K, Chang YS (2012) Laccase-catalysed oxidations of naturally occurring phenols: from in vivo biosynthetic pathways to green synthetic applications. Microb Biotechnol 5:318–332. https://doi.org/10.1111/j.1751-7915.2011.00273.x
Jordaan J (2005) Isolation and characterization of a novel thermostable and catalytically efficient laccase from Peniophora sp. Strain UD4. Dissertation, Rhodes University
Kudanga T, Nemadziva B, Le Roes-Hill M (2017) Laccase catalysis for the synthesis of bioactive compounds. Appl Microbiol Biotechnol 101:13–33. https://doi.org/10.1007/s00253-016-7987-5
Leontievsky A, Myasoedova N, Pozdnyakova N, Golovleva L (1997) ‘Yellow’ laccase of Panus tigrinus oxidizes non-phenolic substrates without electron-transfer mediators. FEBS Lett 413:446–448. https://doi.org/10.1016/S0014-5793(97)00953-8
Li XZ, Cheng Q, Wu YC, Feng YZ, Liu WW, Lin XG (2014a) Influencing factors and product toxicity of anthracene oxidation by fungal laccase. Pedosphere 24:359–366. https://doi.org/10.1016/S1002-0160(14)60022-9
Li XZ, Wang Y, Wu SJ, Qiu L, Gu L, Li J, Zhang B, Zhong W (2014b) Peculiarities of metabolism of anthracene and pyrene by laccase-producing fungus Pycnoporus sanguineus H1. Biotechnol Appl Biochem 61:549–554. https://doi.org/10.1002/bab.1197
Licht HHD, Boomsma JJ, Tunlid A (2014) Symbiotic adaptations in the fungal cultivar of leaf-cutting ants. Nat Commun 5:5675. https://doi.org/10.1038/ncomms6675
Madhavi V, Lele SS (2009) Laccase: properties and applications. Bioresources 4:1694–1717
Marim RA, Oliveira ACC, Marquezoni RS et al (2016) Use of sugarcane molasses by Pycnoporus sanguineus for the production of laccase for dye decolorization. Genet Mol Res 15:gmr15048972. https://doi.org/10.4238/gmr15048972
Montgomery DC (1991) Diseño y análisis de experimentos. Iberoamérica, Ciudad de México
Munusamy US, Muniandy V, Abdullah S, Pandey N, A Jones EBG (2008) Biodegradation of polycyclic aromatic hydrocarbons by laccase of Pycnoporus sanguineus and toxicity evaluation of treated PAH. Biotechnol 7:669–677. https://doi.org/10.3923/biotech.2008.669.677
Myers RH, Montgomery DC, Anderson-Cook CM (2009) Response surface methodology: process and product optimization using designed experiments. John Wiley & Sons, Hoboken
Pozdnyakova NN, Turkovskaya OV, Yudina EN, Rodakiewicz-Nowak Y (2006) Yellow laccase from the fungus Pleurotus ostreatus D1: purification and characterization. Appl Biochem Microbiol 42:56–61. https://doi.org/10.1134/S000368380601008X
Prasetyo EN, Semlitsch S, Nyanhongo GS, Lemmouchi Y, Guebitz GM (2016) Laccase oxidation and removal of toxicants released during combustion processes. Chemosphere 144:652–660. https://doi.org/10.1016/j.chemosphere.2015.07.082
Riva S (2006) Laccases: blue enzymes for green chemistry. Trends Biotechnol 24:219–226. https://doi.org/10.1016/j.tibtech.2006.03.006
Sharma M, Chaurasia PK, Yadav A, Yadav RSS, Yadava S, Yadav KDS (2016) Purification and characterization of a thermally stable yellow laccase from Daedalea flavida MTCC-145 with higher catalytic performance towards selective synthesis of substituted benzaldehydes. Russ J Bioorgan Chem 42:59–68. https://doi.org/10.1134/S1068162016010143
Tien M, Kirk T (1988) Lignin peroxidase of Phanerochaete chrysosporium. In: Wood W, Kellogg S (eds) Methods in enzymologybiomass, part b, lignin, pectin, and chitin. Academic Press, San Diego
Wolfenden BS, Willson RL (1982) Radical-cations as reference chromogens in kinetic studies of ono-electron transfer reactions: pulse radiolysis studies of 2,2′-azinobis-(3-ethylbenzthiazoline-6-sulphonate). J Chem Soc Perkin 2(7):805–812. https://doi.org/10.1039/P29820000805
Xu F (1997) Effects of redox potential and hydroxide inhibition on the pH activity profile of fungal laccases. J Biol Chem 272:924–928. https://doi.org/10.1074/jbc.272.2.924
Zeng J, Zhu QH, Wu YC, Lin XG (2016) Oxidation of polycyclic aromatic hydrocarbons using Bacillus subtilis CotA with high laccase activity and copper independence. Chemosphere 148:1–7. https://doi.org/10.1016/j.chemosphere.2016.01.019
Funding
PTLI and WGB (grant no. 141656/2014-0) thank to Coordenação de Aperfeiçoamento de Pessoal de Nível Superior (CAPES) and to Conselho Nacional de Desenvolvimento Científico e Tecnológico (CNPq) for their scholarships, respectively. The authors also thank CNPq (grant no. 558062/2009-1) and Fundação de Amparo à Pesquisa do Estado de São Paulo (FAPESP, grant no. 2012/19934-0) for financial support.
Author information
Authors and Affiliations
Corresponding author
Ethics declarations
Conflict of interest
The authors declare that they have no conflict of interest.
Ethical approval
This article does not contain any studies with human participants or animals performed by any of the authors.
Additional information
Responsible editor: Gerald Thouand
Publisher’s note
Springer Nature remains neutral with regard to jurisdictional claims in published maps and institutional affiliations.
Electronic supplementary material
ESM 1
(PDF 114 kb)
Rights and permissions
About this article
Cite this article
Ike, P.T.L., Birolli, W.G., dos Santos, D.M. et al. Biodegradation of anthracene and different PAHs by a yellow laccase from Leucoagaricus gongylophorus. Environ Sci Pollut Res 26, 8675–8684 (2019). https://doi.org/10.1007/s11356-019-04197-z
Received:
Accepted:
Published:
Issue Date:
DOI: https://doi.org/10.1007/s11356-019-04197-z